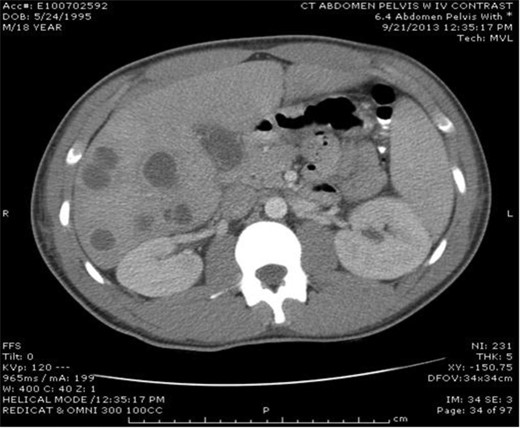
Multiple lucencies noted within the liver consistent with abscesses along with a thickened gallbladder.

-
PDF
- Split View
-
Views
-
Cite
Cite
Dena A. Mentel, Danielle B. Cameron, Shea C. Gregg, Walter Cholewczynski, Alisa Savetamal, Roselle E. Crombie, Paul P. Possenti, Nabil A. Atweh, A case of pyogenic liver abscesses in a previously healthy adolescent man, Journal of Surgical Case Reports, Volume 2014, Issue 11, November 2014, rju118, https://doi.org/10.1093/jscr/rju118
Close - Share Icon Share
Abstract
An 18-year-old, previously healthy man admitted with abdominal pain, high-grade fevers, nausea and emesis was found to have multiple hepatic abscesses. Aspiration cultures grew Fusobacterium necrophorum, a rare bacterium causing potentially fatal liver abscesses in humans. Following sequential percutaneous drainages and narrowing of antibiotics, the patient was discharged on a 6-week antibiotic course and showed no signs of infection. A week after presentation it was discovered that he had experienced upper respiratory symptoms and sore throat prior to presentation. Because oropharyngeal infections are a potential source of bacteremia, they must be considered in the differential diagnosis of patients presenting with hepatic abscesses and no evidence of immunocompromise.
INTRODUCTION
Pyogenic liver abscesses in the adolescent population are rare. The following is an unusual case of multiple liver abscesses that grew Fusobacterium necrophorum, an anaerobic gram-negative rod that is commonly found among human oropharyngeal flora.
CASE REPORT
An 18-year-old, previously healthy college student presented to our hospital with a chief complaint of abdominal pain. He also reported 4 days of high-grade fevers, nausea and emesis. A computed tomography scan of the abdomen with IV contrast at an outside institution showed multiple hepatic abscesses (Fig. 1). Aside from several days of upper respiratory symptoms and odynophagia, a review of systems was negative. He denied any alcohol, illicit drug or tobacco use. On initial examination, the patient was tachycardic, normotensive and febrile to 39.2°C. Aside from minimal right upper quadrant tenderness, the remainder of the physical examination was normal. He had no dental disease. Laboratory data showed leukocytosis of 25 000/µl, erythrocyte sedimentation rate (ESR) 66, International Normalized Ratio 1.41, aspartate transaminase 32, alanine transaminase 50, alkaline phosphatase 147 and direct bilirubin 0.5. A transthoracic echocardiogram showed no valvular lesions.
The patient was started on broad-spectrum antibiotics and underwent ultrasound-guided percutaneous drainage of the largest hepatic abscess, which measured 5 cm (Fig. 2A). The aspiration cultures grew Fusobacterium necrophorum. Despite directed antibiotic therapy, the patient developed worsening tachypnea, fevers, abdominal pain and leukocytosis. A repeat abdominal ultrasound showed an increase in the size of the hepatic abscess. Two additional drainage procedures were performed on hospital Days 7 and 9, which ultimately drained 15 of the collections and removed >120 ml of purulent fluid (Fig. 2B and C). No organisms grew from cultures of the subsequent hepatic aspirations, and the patient demonstrated significant clinical improvement with resolution of pain and fever. Repeat ultrasound on hospital Day 12 showed complete resolution of most hepatic abscesses with no new focal lesions. Antibiotic coverage was further narrowed, and the patient was discharged on a 6-week total course of antibiotics. At the time of this report, the patient continues to do well at home.
DISCUSSION
Pyogenic liver abscesses in the adolescent population are uncommon, particularly in patients who are not immunocompromised and are from developed countries. The annual incidence of pyogenic liver abscesses is 3.6 per 100 000 in the USA, and the majority represents hepatic abscesses in children [1, 2]. The typical clinical manifestations of pyogenic hepatic abscesses are fevers (89.6%), right upper quadrant pain (72.2%) and chills (69.0%) [3]. A single abscess is often insidious in presentation, but multiple abscesses may present more acutely [4]. Laboratory values typically show microcytic anemia, leukocytosis and elevated ESR [5]. Liver function tests are typically normal. Definitive diagnosis is made with ultrasound [5]. Until the 1980s, standard treatment was open surgical debridement, however; with improved antibiotic coverage and image-guided catheter drainage technique, most pyogenic abscesses can successfully be managed with intravenous antibiotics and percutaneous drainage [6].
Multiple lucencies noted within the liver consistent with abscesses along with a thickened gallbladder.

(A) Ultrasonography following initial drainage showing several residual abscesses within the liver, but decreased in number compared with prior exam. (B and C) Ultrasound demonstrating interval improvement in the multiple liver abscesses, with the majority becoming smaller in size and some demonstrating complete resolution.
Classically, liver abscesses in children were described as secondary to a perforated appendicitis; though there is reported increasing incidence of seeding from the biliary tract [4]. The abscesses are thought to result from organisms via three major routes: the biliary tract (60%), portal vein (6%) and the hepatic artery (10%) [7]. In assessing our patient, we primarily considered these routes of transmission when trying to isolate a potential source of infection, with the most common microorganisms isolated from pyogenic liver abscesses being Streptococcus milleri, Staphylococcus aureus, E. coli, Klebsiella pneumonia and Enterobacter [8]. When no predisposing pathology was found, we began to consider other less likely routes of transmission.
A less common microorganism found in pyogenic liver abscesses is F. necrophorum, a gram-negative obligate anaerobe that is found in the oropharynx, gastrointestinal tract and genitourinary tract [9]. Fusobacterium as an isolated infection is relatively rare; accounting for <1% of bacteremia in all adults in the USA [9]. It was first described in animals and there have been very few reports in the literature of human infection [9]. Fusobacterium necrophorum is most commonly associated with Lemierre's syndrome, a potentially life-threatening illness that begins as an oropharyngeal infection that leads to internal or external jugular venous thrombophlebitis and progresses to sepsis with embolic metastasis to the lungs and other organs [10]. It is often referred to as the ‘forgotten disease’ because the widespread use of antibiotics has decreased the incidence, though in the last decade it has begun to re-emerge [1]. A recent polymerase chain reaction study detected the organism in throat swabs from 21% of healthy young adults [9]. Interestingly, these cases seem to be increasing incidence with decreasing usage of antibiotics, especially with practice guidelines that effectively require demonstration of Group A streptococcus before prescribing an antibiotic in children and adults [9].
To date, there have been only two reports that describe liver abscesses in previously healthy adolescent caused by F. necrophorum without associated Lemierre's [1]. There are only four reports overall that suggest oropharyngeal source as a cause for hepatic abscesses [7]. In the presented case, there was a history of upper respiratory symptoms prior to presentation. This is a reminder that one must consider F. necrophorum and oropharyngeal bacterial seeding in an otherwise healthy patient presenting with abscess. Several reports have indicated a relationship between organ abscesses and oral infections, poor oral health and dental interventions or oral prophylaxis [7]. With periodontitis rapidly becoming one of the most common chronic infections in the world, it is important to recognize the association between F. necrophorum and pyogenic hepatic abscess [7].
Currently, there is no standard duration of antibiotic therapy for the treatment of F. necrophorum liver abscesses. The current literature states that patients may require between 4 and 6 weeks of antibiotic therapy with 2–6 weeks of parenteral therapy [1]. Fusobacterium is highly sensitive to antibiotics; however, the inflammatory response the body mounts can cause significant illness thus requiring long-term treatment. In the case of our patient, while he was treated with antibiotics for negative cultures, it was likely the repeated aspirations that diminished his inflammatory response.
Additionally, the extent of percutaneous drainages required for pyogenic liver abscesses has not been clearly delineated in the literature. Case et al. [1] described an adolescent with an F. necrophorum liver abscess who underwent two CT-guided percutaneous drainages with antibiotic treatment and was successfully treated. The difference between this report and our patient was the decision to leave a catheter in place. The utility of a percutaneous drainage catheter was not explored in this case report; and it is possible that a catheter would have been beneficial to our patient and decreased the number of drainages that he underwent.
In conclusion, this case report represents an unusual presentation of Fusobacterium infection leading to hepatic abscess. Given the increased incidence of oropharyngeal infections in children and adolescents, one must consider this and other oropharyngeal sources in the differential for hepatic abscesses with no evidence of immunocompromise or prior intra-abdominal procedures.
CONFLICT OF INTEREST STATEMENT
Dr. Gregg has received an honorarium for teaching ATLS for the American College of Surgeons. All other authors report no conflict of interest.